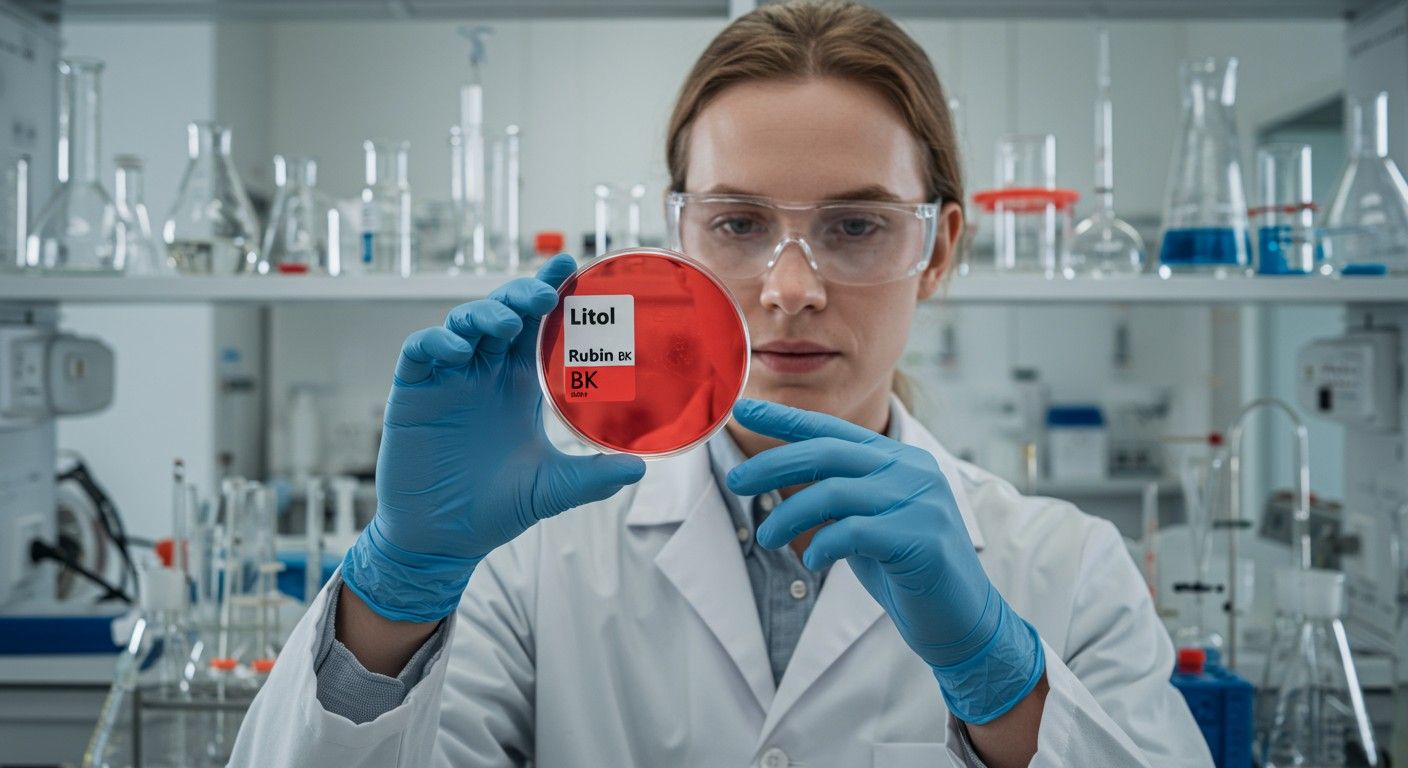
A Litol rubin BK tartós és hőálló, de drága.

A szerves pigmentek világa rendkívül gazdag és sokszínű, esszenciális szerepet játszva mindennapi életünk számos területén. Ezek a vegyületek felelősek a színekért, amelyekkel találkozunk a nyomtatott anyagoktól kezdve a műanyag termékeken át egészen a kozmetikumokig. Ezen pigmentek között kiemelkedő helyet foglal el a Litol rubin BK, egy szintetikus azo pigment, amely a vörös árnyalatok egyik leggyakrabban használt képviselője az iparban. A CI Pigment Red 57:1 néven is ismert vegyület egy kalcium-só, melynek egyedi szerkezete és tulajdonságai teszik alkalmassá széleskörű alkalmazásokra.
A pigmentek története az emberiség hajnaláig nyúlik vissza, amikor természetes ásványokat és növényi kivonatokat használtak a színek előállítására. A modern kémia fejlődésével azonban megnyílt az út a szintetikus pigmentek előállítása felé, amelyek sokkal konzisztensebb minőséget, jobb teljesítményt és szélesebb színválasztékot kínáltak. A Litol rubin BK az 1900-as évek elején jelent meg, és gyorsan népszerűvé vált kedvező ár-érték arányának és élénk, tiszta vörös színének köszönhetően. Ez a pigment máig az egyik legfontosabb vörös színezék az iparban, különösen a nyomdaiparban és a műanyagfeldolgozásban.
Ez a mélyreható elemzés bemutatja a Litol rubin BK kémiai szerkezetét, részletesen kitér fizikai és kémiai tulajdonságaira, beleértve a fény-, hő- és oldószerállóságát, valamint a színjellemzőit. Emellett átfogóan ismerteti a pigment legfontosabb felhasználási területeit, a nyomdaipartól a kozmetikumokig, kitérve az egyes iparágak speciális igényeire. Végül, de nem utolsósorban, foglalkozunk a gyártási folyamattal, a minőségellenőrzéssel, valamint a biztonsági és környezetvédelmi szempontokkal, amelyek elengedhetetlenek egy ilyen fontos ipari alapanyag esetében.
A Litol rubin BK kémiai szerkezete és szintézise
A Litol rubin BK, kémiai nevén kalcium-bisz(1-(4-szulfonáto-1-naftilazo)-2-naftolát), egy komplex szerves molekula, amely az azo pigmentek családjába tartozik. Az azo vegyületek jellegzetessége az -N=N- (azo) csoport jelenléte, amely két aromás vagy heterociklusos gyűrűt köt össze. Ez az azo csoport felelős a vegyület intenzív színéért, mivel képes elnyelni a látható fény bizonyos hullámhosszait, és visszaverni a vörös tartományba eső sugarakat.
A Litol rubin BK konkrét szerkezete a 1-naftol és a diazotált 2-amino-5-metilbenzolszulfonsav (más néven 4-amino-3-metilbenzolszulfonsav) kapcsolási reakciójából származik, majd a keletkező színezék kalcium-sójának képződésével stabilizálódik. A molekula két naftolgyűrűt, egy benzolszulfonsav csoportot és egy metilcsoportot tartalmaz, amelyek mind hozzájárulnak a pigment színéhez, stabilitásához és egyéb tulajdonságaihoz. A szulfonát csoport (SO₃⁻) jelenléte kulcsfontosságú a vízoldhatóság szempontjából a színezék prekurzorában, de a végtermék, a kalcium-só, vízben lényegében oldhatatlan, ami pigmentként való alkalmazhatóságának alapja.
A Litol rubin BK kémiai képlete általában C₁₈H₁₂CaN₂O₆S. A kalciumion (Ca²⁺) két szulfonátcsoporttal képez ionos kötést, stabilizálva a molekulát és biztosítva a pigment formát. Ez a kalcium-só szerkezet adja a pigment nevét is, utalva a rubin árnyalatú színre és a kalcium (K) jelenlétére. A pontos kémiai elnevezés és a szerkezeti részletek kulcsfontosságúak a vegyület viselkedésének megértéséhez a különböző alkalmazásokban.
A Litol rubin BK egy kalcium-só, melynek azo csoportja felelős a vibráló vörös színért, a szulfonát csoport pedig a vízoldhatatlanságért pigment formájában.
A pigment szintézisének alapja egy úgynevezett diazotálási és kapcsolási reakció. Először is, a 2-amino-5-metilbenzolszulfonsavat nátrium-nitrittel és sósavval reagáltatják alacsony hőmérsékleten, diazóniumsóvá alakítva. Ez a diazóniumsó rendkívül reaktív, és azonnal reagál a 1-naftollal egy kapcsolási reakcióban. Ez a reakció hozza létre az azo kötést és a szerves színezék molekulát.
Ezt követően a keletkezett színezék oldatát kalcium-kloriddal vagy más kalcium-sóval kezelik. Ennek hatására a vízoldható színezékből vízben oldhatatlan kalcium-só válik, ami kicsapódik a reakcióelegyből. Ez a kicsapódás, vagyis a pigmentáció kulcsfontosságú lépés, mivel ez határozza meg a pigment részecskeméretét, kristályszerkezetét és ezáltal a végtermék fizikai tulajdonságait, mint például a színezőerőt, az opacitást és a diszpergálhatóságot. A gondos szabályozás ezen a ponton elengedhetetlen a konzisztens minőség eléréséhez.
A gyártási folyamat során a pH, a hőmérséklet, a reagens koncentrációja és a keverési sebesség mind befolyásolják a végtermék tulajdonságait. A kristálynövekedés és a felületkezelés további lépések, amelyek optimalizálhatják a pigment teljesítményét. Például, speciális felületkezelő anyagok hozzáadásával javítható a pigment diszpergálhatósága különböző hordozóanyagokban, például olajokban vagy polimerekben, ezáltal növelve az alkalmazási rugalmasságot és a végtermék minőségét.
Fizikai és kémiai tulajdonságok részletesen
A Litol rubin BK széles körű ipari alkalmazhatósága a specifikus fizikai és kémiai tulajdonságainak köszönhető. Ezek a tulajdonságok határozzák meg, hogyan viselkedik a pigment különböző környezetekben és anyagokkal érintkezve, befolyásolva a végtermék esztétikai és funkcionális jellemzőit.
Színárnyalat és spektrális jellemzők
A Litol rubin BK egy mély, élénk, tiszta rubin vörös árnyalatot biztosít. Színprofilja a sárgás-vörös és a kékes-vörös tartomány közötti, jellegzetes, jól felismerhető színt eredményez. A pontos árnyalat némileg eltérhet a gyártási folyamattól, a részecskemérettől és a felületkezeléstől függően. A pigment spektrális abszorpciója a látható fény vörös tartományában koncentrálódik, ami magyarázza a mély vörös megjelenését. Színezőereje magas, ami azt jelenti, hogy kis mennyiség is elegendő az intenzív szín eléréséhez, gazdaságossá téve a felhasználását.
Az opacitás és a transzparencia a pigment részecskeméretétől és a diszperziójától függ. Általában a Litol rubin BK közepesen opac pigment, de finomabb őrléssel és megfelelő diszperzióval transzparensebb hatás is elérhető. Ez a rugalmasság lehetővé teszi, hogy különböző alkalmazásokban, mint például a nyomdaiparban, ahol az átlátszóság és a fedőképesség egyaránt fontos lehet, hatékonyan alkalmazzák.
Fényállóság
A Litol rubin BK fényállósága közepesnek mondható. Ez azt jelenti, hogy hosszabb ideig tartó erős fénynek, különösen UV sugárzásnak kitéve, hajlamos a fakulásra. A fényállóságot általában egy 1-től 8-ig terjedő skálán értékelik (kékgyapjú skála), ahol a 8 a kiváló, az 1 pedig a nagyon gyenge fényállóságot jelenti. A Litol rubin BK jellemzően 3-4-es értéket mutat, ami elegendő számos beltéri alkalmazáshoz, de korlátozhatja kültéri vagy hosszú távú, közvetlen napfénynek kitett felhasználását. A fényállóság javítható UV-stabilizátorok hozzáadásával a végtermékben, vagy speciális felületkezelési eljárásokkal a pigment gyártása során.
Hőállóság
A pigment hőállósága kritikus paraméter a műanyagiparban, ahol a feldolgozási hőmérsékletek magasak lehetnek. A Litol rubin BK hőállósága szintén közepes, általában 180-200°C közötti tartományban stabil. Ezen hőmérséklet felett hajlamos a bomlásra vagy a színváltozásra, ami elszíneződést vagy a színezőerő csökkenését eredményezheti. Ez a tulajdonság befolyásolja, hogy milyen típusú műanyagokhoz és milyen feldolgozási eljárásokhoz alkalmazható. Például, magasabb olvadáspontú polimerek, mint a polikarbonát, esetében más, hőállóbb pigmentekre lehet szükség.
Oldhatóság és diszperziós képesség
A Litol rubin BK, mint igazi pigment, vízben gyakorlatilag oldhatatlan. Szerves oldószerekben is csak minimálisan oldódik, vagy egyáltalán nem. Ez a tulajdonság alapvető fontosságú, mivel a pigmenteknek stabilan kell diszpergálódniuk a hordozóanyagban anélkül, hogy feloldódnának és elvándorolnának (migráció). A rossz oldhatóság biztosítja, hogy a szín stabilan a helyén maradjon.
A diszperziós képesség azonban kulcsfontosságú. A pigmentnek egyenletesen kell eloszlania a festékben, műanyagban vagy tintában, hogy homogén és intenzív színt biztosítson. A Litol rubin BK általában jól diszpergálható a legtöbb polimerben és kötőanyagban, különösen, ha megfelelő felületkezeléssel látták el. A nem megfelelő diszperzió pontszerű elszíneződést, csíkozódást vagy a színezőerő csökkenését okozhatja.
A pigmentek, mint a Litol rubin BK, nem oldódnak a hordozóanyagban; ehelyett finom részecskék formájában oszlanak el, biztosítva a stabil és tartós színt.
Sav- és lúgállóság
A Litol rubin BK sav- és lúgállósága szintén közepes. Erős savak és lúgok hatására hajlamos a színváltozásra vagy a bomlásra. Ezért olyan alkalmazásokban, ahol a pH extrém értékeket vehet fel, óvatosan kell eljárni. Élelmiszer-csomagolásban például, ahol savas vagy lúgos élelmiszerekkel érintkezhet, a stabilitás alapos vizsgálata szükséges. A semleges pH tartományban azonban stabilan viselkedik.
Olajabszorpció és sűrűség
Az olajabszorpció azt mutatja meg, mennyi olajat képes felvenni a pigment egységnyi tömege, ami befolyásolja a festékek vagy tinták viszkozitását és reológiai tulajdonságait. A Litol rubin BK olajabszorpciója tipikusan közepes, ami kedvező számos alkalmazáshoz. Sűrűsége általában 1.5 – 1.8 g/cm³ között mozog, ami szintén standard érték a szerves pigmentek között.
Toxicitás és biztonsági adatok
A Litol rubin BK-t általában biztonságosnak tartják a legtöbb ipari alkalmazásban, feltéve, hogy a megfelelő óvintézkedéseket betartják. Nem sorolható a veszélyes anyagok közé a legtöbb globális szabályozás szerint. Ugyanakkor, mint minden finom por esetében, belélegezve irritációt okozhat. A gyártóknak és felhasználóknak mindig be kell tartaniuk az Anyagbiztonsági Adatlapban (MSDS/SDS) foglalt utasításokat, amelyek részletezik a biztonságos kezelést, tárolást és ártalmatlanítást. Az élelmiszerekkel és kozmetikumokkal érintkező alkalmazásokban különösen szigorú tisztasági és toxikológiai előírásoknak kell megfelelnie.
Fontos megjegyezni, hogy bár a Litol rubin BK önmagában nem tekinthető rendkívül toxikusnak, a gyártási folyamat során keletkező melléktermékek vagy a nem megfelelő tisztasági fokú pigmentek tartalmazhatnak szennyeződéseket, amelyek aggodalomra adhatnak okot. Ezért a gyártói minőségellenőrzés és a szabályozásoknak való megfelelés kiemelten fontos.
Kristályszerkezet és részecskeméret-eloszlás
A Litol rubin BK kristályszerkezete és részecskeméret-eloszlása jelentősen befolyásolja a pigment optikai tulajdonságait, mint például a színezőerő, az opacitás, a fényállóság és a diszpergálhatóság. A finomabb részecskeméret általában nagyobb színezőerőt és transzparenciát eredményez, míg a durvább részecskék növelhetik az opacitást és javíthatják a diszpergálhatóságot bizonyos rendszerekben. A gyártási folyamat során a kristálynövekedés és az őrlés finomhangolásával lehet a kívánt részecskeméret-eloszlást elérni, optimalizálva a pigment teljesítményét a specifikus alkalmazási területeken.
A Litol rubin BK felhasználási területei
A Litol rubin BK rendkívül sokoldalú pigment, amely széles körben alkalmazott számos iparágban, köszönhetően élénk színének, jó színezőerejének és viszonylag kedvező árának. Az alábbiakban részletesen bemutatjuk a legfontosabb felhasználási területeket.
Nyomdaipar
A nyomdaipar az egyik legnagyobb felhasználója a Litol rubin BK-nak. Különösen népszerű az ofszet, flexo és mélynyomtatásban, ahol a magas színezőerő és a tiszta vörös árnyalat elengedhetetlen. A pigmentet gyakran használják magazinok, brosúrák, katalógusok, csomagolóanyagok és címkék nyomtatásához. Kiválóan alkalmas a magenta alapszín komponenseként a CMYK (cián, magenta, sárga, fekete) négyszínnyomásban, hozzájárulva a széles színskála reprodukálásához.
A nyomdaipari tintákban a pigmentnek stabilan kell diszpergálódnia az olaj alapú vagy vizes kötőanyagokban, és gyorsan kell száradnia a nyomtatási folyamat során. A Litol rubin BK ezen tulajdonságai miatt kiváló választás, bár a fényállóságát figyelembe kell venni olyan termékek esetében, amelyek hosszú távon napfénynek vannak kitéve, például kültéri plakátoknál. A pigment jó kompatibilitást mutat a különböző gyantákkal és oldószerekkel, ami megkönnyíti a tintaformulációk elkészítését.
Műanyagipar
A műanyagipar a Litol rubin BK másik jelentős felhasználója. Számos polimer színezésére alkalmas, beleértve a PVC-t (polivinil-klorid), poliolefineket (polietilén, polipropilén), polisztirolt (PS) és ABS-t (akrilnitril-butadién-sztirol). A pigmentet széles körben alkalmazzák játékok, háztartási cikkek, csomagolóanyagok, építőipari profilok, kábelek és autóipari alkatrészek gyártásánál.
A műanyagok színezésekor a pigmentnek magas hőállósággal kell rendelkeznie, hogy ellenálljon a fröccsöntési, extrudálási vagy fúvási folyamatok magas hőmérsékletének. Bár a Litol rubin BK hőállósága közepes, elegendő a legtöbb általános műanyag feldolgozási hőmérsékletéhez. Fontos szempont a migráció is: egyes pigmentek hajlamosak kivándorolni a polimer mátrixból, ami elszíneződést vagy foltosodást okozhat. A Litol rubin BK esetében a migrációs hajlamot figyelembe kell venni, különösen puhított PVC-ben. A megfelelő pigmentkoncentráció és a polimer típusa befolyásolja ezt a jelenséget.
A Litol rubin BK élénk vörös árnyalata és gazdaságossága teszi ideálissá a nyomda- és műanyagipar számára, ahol a színintenzitás és a költséghatékonyság kulcsfontosságú.
Festékipar és bevonatok
A festékiparban a Litol rubin BK ipari festékekben, dekoratív festékekben és bevonatokban egyaránt megtalálható. Használják beltéri falfestékek, fa- és fémbevonatok, valamint művészfestékek színezésére. A pigment jó diszpergálhatósága és színezőereje előnyös a festékformulációkban, ahol a szín stabilitása és tartóssága fontos. Kültéri alkalmazásokban, ahol a fényállóság kritikus, gyakran más, stabilabb vörös pigmentekkel kombinálva vagy helyettük alkalmazzák.
A bevonatok esetében a pigmentnek ellenállónak kell lennie a kémiai hatásoknak és a környezeti tényezőknek. Bár a Litol rubin BK sav- és lúgállósága közepes, megfelelő kötőanyagokkal és adalékanyagokkal stabilizálható, hogy megfeleljen az adott alkalmazás követelményeinek. Az esztétikai szempontok mellett a funkcionális bevonatokban is szerepet játszhat, ahol a színjelölés vagy az azonosítás a cél.
Kozmetikumok
Bizonyos tisztasági fokú Litol rubin BK változatokat engedélyeznek a kozmetikai iparban, különösen rúzsok, körömlakkok, pirosítók és egyéb sminktermékek színezésére. Azonban itt rendkívül szigorú előírások vonatkoznak a pigment tisztaságára és toxikológiai profiljára. A kozmetikai minőségű pigmenteknek mentesnek kell lenniük nehézfémektől és egyéb szennyeződésektől, amelyek károsak lehetnek az emberi egészségre.
A kozmetikai alkalmazásokban a pigmentnek jó diszpergálhatósággal kell rendelkeznie a különböző olajokban, viaszokban és egyéb kozmetikai alapanyagokban. Emellett fontos a bőrrel való kompatibilitás, az irritációmentesség és az allergén hatás hiánya. A Litol rubin BK kozmetikai felhasználása szigorú szabályozás és ellenőrzés alatt áll, hogy biztosítsák a fogyasztók biztonságát.
Egyéb alkalmazások
A Litol rubin BK egyéb iparágakban is felhasználást talál, bár kisebb mértékben. A gumigyártásban például a gumi termékek színezésére használják, ahol a pigmentnek ellenállónak kell lennie a vulkanizálási folyamat magas hőmérsékletének és a kémiai környezetnek. A papíriparban is alkalmazható a papírpép vagy a felületi bevonatok színezésére, ahol a kívánt vörös árnyalat elérése a cél. Emellett bizonyos textilnyomtatási eljárásokban is használhatják, bár a textíliák közvetlen színezésére általában más típusú színezékeket, például direkt vagy reaktív festékeket alkalmaznak.
Összességében a Litol rubin BK egy igazi ipari „munkaló” a pigmentek között, amelynek sokoldalúsága és gazdaságossága biztosítja folyamatosan magas keresletét a globális piacon. Az alkalmazási területek széles skálája mutatja be, mennyire alapvető fontosságú ez a vegyület a modern termékek színvilágának megteremtésében.
A Litol rubin BK előnyei és korlátai
Minden ipari alapanyagnak megvannak a maga erősségei és gyengeségei. A Litol rubin BK sem kivétel, és az iparágakban betöltött szerepét az előnyei és korlátai együttesen határozzák meg. Ezeknek a tényezőknek a megértése kulcsfontosságú a pigment optimális kiválasztásához és felhasználásához.
Előnyei
A Litol rubin BK számos előnyös tulajdonsággal rendelkezik, amelyek hozzájárulnak széles körű népszerűségéhez és alkalmazhatóságához:
- Élénk és tiszta színárnyalat: A pigment mély, intenzív rubin vörös színt biztosít, amely esztétikailag vonzó és jól reprodukálható. Ez a tiszta vörös árnyalat különösen fontos a nyomdaiparban, ahol a színpontosság alapvető.
- Magas színezőerő: Kis mennyiségű pigment is elegendő az intenzív szín eléréséhez, ami gazdaságossá teszi a felhasználását. Ez csökkenti a gyártási költségeket és a felhasznált anyag mennyiségét.
- Költséghatékony: Az egyik legkedvezőbb árú vörös pigment a piacon, ami különösen vonzóvá teszi a nagy volumenű alkalmazások számára, ahol a költséghatékonyság kiemelten fontos. Ez a gazdasági előny gyakran felülírja a prémium pigmentek jobb, de drágább teljesítményét.
- Jó diszpergálhatóság: A legtöbb kötőanyagban és polimerben viszonylag könnyen és egyenletesen eloszlik, ami homogén színezést és kiváló színmegjelenést eredményez. A megfelelő diszperzió minimalizálja a csíkozódást és a foltosodást.
- Széleskörű alkalmazhatóság: Ahogy azt már említettük, a nyomdaipartól a műanyagiparon át a festékiparig és kozmetikumokig számos területen felhasználható. Ez a sokoldalúság rugalmasságot biztosít a gyártóknak.
- Stabilitás a feldolgozás során: Bár a hőállósága közepes, a legtöbb standard feldolgozási hőmérsékleten stabil marad, különösen a nyomdaipari és alacsonyabb hőmérsékletű műanyagipari alkalmazásokban.
A Litol rubin BK a költséghatékonyság, az élénk szín és a magas színezőerő ideális kombinációját kínálja, ami miatt az egyik leggyakrabban választott vörös pigment az iparban.
Korlátai
Az előnyök mellett fontos figyelembe venni a Litol rubin BK korlátait is, amelyek befolyásolhatják az alkalmazási döntéseket:
- Közepes fényállóság: Ez a pigment egyik legjelentősebb korlátja. Hosszabb ideig tartó napfénynek vagy UV sugárzásnak kitéve hajlamos a fakulásra. Ez korlátozza kültéri alkalmazásokban vagy olyan termékekben való használatát, amelyek hosszú távon erős fénynek vannak kitéve.
- Közepes hőállóság: Magasabb feldolgozási hőmérsékleten (általában 200°C felett) bomolhat vagy színváltozást mutathat. Ez kizárja bizonyos magas olvadáspontú polimerek (pl. polikarbonát, egyes mérnöki műanyagok) színezéséből.
- Migrációs hajlam: Bizonyos polimerekben, különösen a lágyított PVC-ben, a pigment hajlamos lehet a migrációra, azaz kivándorolhat a polimer mátrixból a felületre vagy más rétegekbe. Ez elszíneződést, foltosodást és a termék esztétikai minőségének romlását okozhatja.
- Korlátozott sav- és lúgállóság: Erős savak és lúgok hatására a pigment színváltozást mutathat vagy bomolhat. Ez limitálja olyan környezetekben való felhasználását, ahol szélsőséges pH értékek fordulnak elő.
- Környezetvédelmi és egészségügyi aggályok a gyártás során: Bár maga a végtermék, a pigment, általában biztonságosnak minősül, a gyártási folyamat során felhasznált alapanyagok és keletkező melléktermékek környezetvédelmi szempontból aggodalomra adhatnak okot. A fenntartható gyártási gyakorlatok és a szennyezés csökkentése folyamatos kihívást jelent.
- Tisztasági követelmények: Különösen az élelmiszerrel érintkező és kozmetikai alkalmazásokban, ahol szigorú tisztasági előírásoknak kell megfelelni, a standard ipari minőségű Litol rubin BK nem mindig megfelelő. Speciális, magas tisztaságú változatokra van szükség, amelyek drágábbak és speciális gyártási eljárásokat igényelnek.
Ezen korlátok ellenére a Litol rubin BK továbbra is rendkívül fontos pigment marad. Az iparágak gyakran kompromisszumot keresnek a teljesítmény, az ár és a specifikus alkalmazási követelmények között. Ahol a közepes fény- és hőállóság elfogadható, és a migrációs kockázat kezelhető, ott a Litol rubin BK ideális és gazdaságos választásnak bizonyul.
Gyártási folyamat és minőségellenőrzés
A Litol rubin BK gyártása egy komplex kémiai folyamat, amely több lépésből áll, és gondos ellenőrzést igényel a konzisztens minőség elérése érdekében. A gyártási folyamat optimalizálása és a szigorú minőségellenőrzés elengedhetetlen a végtermék teljesítményének és biztonságának garantálásához.
Nyersanyagok és előkészítés
A Litol rubin BK szintéziséhez szükséges fő nyersanyagok a 2-amino-5-metilbenzolszulfonsav (vagy 4-amino-3-metilbenzolszulfonsav), a 1-naftol, nátrium-nitrit, sósav és kalcium-klorid. Ezeknek az alapanyagoknak a tisztasága és minősége alapvetően befolyásolja a végtermék tulajdonságait. Az előkészítési fázis magában foglalja a nyersanyagok pontos bemérését és oldatokká történő előkészítését, a koncentrációk és a hőmérsékletek szigorú ellenőrzése mellett.
Szintetizálási lépések
1. Diazotálás: Az első kulcsfontosságú lépés a 2-amino-5-metilbenzolszulfonsav diazotálása. Ebben a reakcióban az aminocsoportot diazóniumcsoporttá alakítják nátrium-nitrit és sósav segítségével alacsony hőmérsékleten (általában 0-5°C). A diazóniumsó instabil, ezért azonnal fel kell használni a következő lépésben.
2. Kapcsolás: A diazóniumsó oldatát lassan hozzáadják a 1-naftol oldatához, amely általában lúgos környezetben van. Ebben a lépésben jön létre az azo kötés, és kialakul a színezék molekula. A reakciót szintén ellenőrzött hőmérsékleten és pH-n végzik, hogy optimalizálják a hozamot és a termék tisztaságát. A kapcsolási reakció sebessége és a körülmények befolyásolják a részecskeméret kezdeti eloszlását.
3. Pigmentáció (só képzés): A keletkezett vízoldható színezék oldatához kalcium-klorid vagy más kalcium-só oldatát adják hozzá. Ennek hatására a szulfonátcsoportok kalciumionokkal képeznek ionos kötést, ami a színezék vízoldhatatlanná válását és pigmentként való kicsapódását eredményezi. Ez a lépés kritikus a pigment kristályszerkezetének és részecskeméretének kialakításában. A pH, a hőmérséklet és a kalcium-só adagolásának sebessége mind befolyásolja a végtermék tulajdonságait.
Utókezelés és finomítás
A kicsapódott pigment szuszpenzióját ezután feldolgozzák a kívánt részecskeméret és felületi tulajdonságok elérése érdekében:
1. Szűrés és mosás: A pigmentet szűréssel választják el a vizes fázistól, majd alaposan mossák, hogy eltávolítsák a melléktermékeket, a felesleges sókat és a szennyeződéseket. A mosás tisztább pigmentet eredményez, ami javítja a fényállóságot és csökkenti a migrációs hajlamot.
2. Szárítás: A mosott pigmentpasztát ezután szárítják. A szárítási mód (pl. permetezéses szárítás, vákuumszárítás) és a hőmérséklet befolyásolja a pigment agglomerációját és végső részecskeméretét.
3. Őrlés és diszpergálás: A szárított pigmentet őrléssel finomítják, hogy elérjék a kívánt részecskeméret-eloszlást. Ez a lépés kulcsfontosságú a színezőerő, az opacitás és a diszpergálhatóság optimalizálásához. Néha felületkezelő anyagokat is adnak hozzá az őrlés során, hogy javítsák a pigment kompatibilitását a különböző hordozóanyagokkal.
4. Standardizálás: Végül a pigmentet standardizálják, azaz szükség esetén keverik más tételekkel, hogy biztosítsák a konzisztens színárnyalatot és színezőerőt a különböző gyártási tételek között.
A Litol rubin BK gyártásának minden lépése, a nyersanyagok tisztaságától a finom őrlésig, kritikus a végtermék minőségének és teljesítményének biztosításában.
Minőségellenőrzés
A szigorú minőségellenőrzés elengedhetetlen a Litol rubin BK gyártása során. A különböző fázisokban mintákat vesznek, és a következő paramétereket ellenőrzik:
- Színmérés: Spektrofotométerrel mérik a pigment színárnyalatát, fényességét (L*a*b* értékek) és színezőerejét, hogy biztosítsák a gyártói specifikációknak való megfelelést. Ezt gyakran referenciamintákhoz viszonyítva végzik.
- Részecskeméret-eloszlás: Lézer diffrakciós vagy mikroszkópos módszerekkel ellenőrzik a pigment részecskeméretét és eloszlását, ami befolyásolja az opacitást, a színezőerőt és a diszpergálhatóságot.
- Nedvességtartalom: A nedvességtartalom meghatározása fontos, mivel a túlzott nedvesség befolyásolhatja a pigment stabilitását és diszpergálhatóságát.
- pH-érték: A pigment szuszpenziójának pH-ja befolyásolhatja a stabilitást és az alkalmazási tulajdonságokat.
- Olajabszorpció: Ez a paraméter segít előre jelezni, hogyan viselkedik a pigment festékekben és tintákban.
- Fény- és hőállóság tesztek: Laboratóriumi körülmények között gyorsított tesztekkel ellenőrzik a pigment fény- és hőállóságát.
- Migrációs tesztek: Különösen műanyagipari felhasználás esetén végzik el a migrációs teszteket, hogy felmérjék a pigment hajlamát a kivándorlásra.
- Tisztasági és toxikológiai vizsgálatok: Különösen a kozmetikai és élelmiszerrel érintkező alkalmazásokhoz szánt pigmentek esetében végeznek részletes analíziseket a nehézfém-tartalom és egyéb potenciálisan káros szennyeződések kimutatására.
A minőségellenőrzési adatok alapján a gyártók biztosítják, hogy a Litol rubin BK minden tétele megfeleljen a szigorú ipari szabványoknak és az ügyfél elvárásainak, garantálva a megbízható és konzisztens teljesítményt.
Biztonsági és környezetvédelmi szempontok
A Litol rubin BK gyártása és felhasználása során számos biztonsági és környezetvédelmi szempontot kell figyelembe venni. A vegyiparban dolgozó vállalatoknak és a pigmentet felhasználó iparágaknak egyaránt be kell tartaniuk a vonatkozó szabályozásokat és a legjobb gyakorlatokat a dolgozók, a fogyasztók és a környezet védelme érdekében.
Egészségügyi és biztonsági kockázatok
A Litol rubin BK, mint finom por, belélegezve irritációt okozhat a légutakban. Bár nem minősül különösen toxikus anyagnak, a hosszú távú vagy nagy koncentrációjú expozíció kerülendő. A pigment kezelése során javasolt a személyi védőfelszerelések (PPE), mint például védőszemüveg, kesztyű és porvédő maszk használata. A por képződését minimalizálni kell, és megfelelő szellőzésről kell gondoskodni a munkahelyeken.
Az Anyagbiztonsági Adatlap (SDS/MSDS) részletes információkat tartalmaz a pigment biztonságos kezeléséről, tárolásáról, a tűzvédelmi előírásokról és az elsősegélynyújtásról. Ezeket az információkat minden felhasználó számára elérhetővé kell tenni, és a dolgozókat rendszeresen oktatni kell a biztonságos munkavégzésre.
Különös figyelmet igényelnek a kozmetikai és élelmiszerrel érintkező alkalmazások. Ezekben az esetekben a pigmentnek sokkal szigorúbb tisztasági követelményeknek kell megfelelnie, és mentesnek kell lennie nehézfémektől és egyéb káros szennyeződésektől. Az Európai Unióban a REACH (Registration, Evaluation, Authorisation and Restriction of Chemicals) rendelet, valamint az élelmiszerrel érintkező anyagokra és kozmetikumokra vonatkozó speciális rendeletek szabályozzák ezeket a területeket.
Környezeti hatások és szabályozások
A Litol rubin BK gyártása során keletkező melléktermékek és szennyvizek környezeti terhelést jelenthetnek. A gyártóknak modern technológiákat kell alkalmazniuk a szennyvíztisztításra és a kibocsátások minimalizálására. A fenntartható gyártási gyakorlatok bevezetése, mint például a víztakarékosság, az energiahatékonyság növelése és a hulladék minimalizálása, egyre fontosabbá válik az iparágban.
A pigment maga vízben oldhatatlan, ami azt jelenti, hogy nem szennyezi a vízi élővilágot oldott formában. Azonban a nem megfelelő ártalmatlanítás, például a hulladéklerakókba kerülő pigmentpor, mechanikai szennyezést okozhat. A pigmentet tartalmazó hulladékokat, mint például a festék- vagy tintamaradványokat, veszélyes hulladékként kell kezelni és szakszerűen ártalmatlanítani a helyi és nemzetközi előírásoknak megfelelően.
Az olyan szabályozások, mint az EU REACH rendelete, kötelezik a gyártókat és importőröket arra, hogy regisztrálják vegyi anyagaikat, és felmérjék azok kockázatait. Ez biztosítja, hogy a vegyi anyagok biztonságos felhasználása során elegendő információ álljon rendelkezésre. A Litol rubin BK esetében is folyamatosan nyomon követik a tudományos fejleményeket és a szabályozási változásokat, hogy garantálják a megfelelőséget.
Alternatívák és fenntarthatóság
A környezettudatosság növekedésével és a szigorodó szabályozásokkal párhuzamosan az iparág folyamatosan keresi a fenntarthatóbb pigmentmegoldásokat. Ez magában foglalhatja a Litol rubin BK alternatíváinak, például bioalapú vagy könnyebben lebomló pigmentek fejlesztését, bár ezek jelenleg gyakran drágábbak vagy nem rendelkeznek azonos teljesítményjellemzőkkel.
A fenntarthatóság szempontjából fontos a pigmentek teljes életciklusának figyelembe vétele, a nyersanyagbeszerzéstől a gyártáson át az ártalmatlanításig. A gyártók egyre inkább törekednek a „zöldebb” kémiára, a kevesebb veszélyes anyagot használó és kevesebb hulladékot termelő folyamatokra. A Litol rubin BK esetében ez magában foglalhatja a gyártási folyamatok optimalizálását, a melléktermékek újrahasznosítását és az energiahatékonyság növelését. A pigmentek újrahasznosítása a végtermékekből, például műanyagokból, szintén egyre inkább kutatott terület.
Összességében a Litol rubin BK, mint sok más ipari vegyi anyag, felelősségteljes kezelést és folyamatos figyelmet igényel a biztonsági és környezetvédelmi szempontok tekintetében. A szabályozásoknak való megfelelés és a fenntartható gyakorlatok bevezetése nemcsak jogi kötelezettség, hanem a vállalatok társadalmi felelősségvállalásának is része.
Piaci trendek és jövőbeli kilátások
A pigmentpiac dinamikusan fejlődik, amelyet számos tényező befolyásol, mint például a globális gazdasági növekedés, a technológiai innovációk, a fogyasztói preferenciák változása és a szigorodó környezetvédelmi szabályozások. A Litol rubin BK, mint az egyik legfontosabb vörös pigment, ezen trendek középpontjában áll.
A pigmentpiac dinamikája
A globális pigmentpiac folyamatosan növekszik, főként az ázsiai-csendes-óceáni térség növekvő ipari termelése és a fejlődő országok urbanizációja miatt. A nyomdaipar, a műanyagipar és a festékipar továbbra is a legnagyobb fogyasztók, de a speciális alkalmazások, mint például a kozmetikumok és a digitális nyomtatás, is egyre nagyobb részt hasítanak ki a piacból.
A Litol rubin BK iránti kereslet stabil maradt, köszönhetően kiváló ár-érték arányának és széleskörű alkalmazhatóságának. Bár a prémium kategóriás, magasabb fény- és hőállóságú pigmentek iránt is növekszik a kereslet bizonyos szegmensekben, a költséghatékony megoldásokra mindig szükség lesz, és ebben a kategóriában a Litol rubin BK megkerülhetetlen szereplő.
A Litol rubin BK a pigmentpiac stabil szereplője marad, köszönhetően gazdaságosságának és sokoldalúságának, miközben az iparág a fenntarthatóbb és innovatívabb megoldások felé mozdul el.
Innovációk a színezékgyártásban
A pigmentgyártók folyamatosan kutatnak és fejlesztenek új technológiákat a pigmentek teljesítményének javítására. Ez magában foglalhatja a Litol rubin BK esetében a részecskeméret-eloszlás finomhangolását, új felületkezelő anyagok kifejlesztését a diszpergálhatóság és a stabilitás javítása érdekében, valamint a gyártási folyamatok optimalizálását a hozam növelése és a környezeti lábnyom csökkentése céljából.
Az innovációk célja gyakran a pigmentek fény- és hőállóságának növelése, a migrációs hajlam csökkentése és a környezetbarát alternatívák fejlesztése. Bár a Litol rubin BK alapvető kémiai szerkezete valószínűleg nem változik drasztikusan, a modern gyártási eljárásokkal és adalékanyagokkal tovább javítható a teljesítménye és alkalmazhatósága. Például, speciális polimer bevonatokkal javítható a pigmentek ellenállása a környezeti hatásokkal szemben.
Fenntartható megoldások keresése
A fenntarthatóság egyre inkább a vegyipar és a pigmentgyártás középpontjába kerül. A fogyasztók és a szabályozó szervek egyaránt nyomást gyakorolnak a gyártókra, hogy csökkentsék termékeik környezeti hatását. Ez a trend a Litol rubin BK-ra is hatással van.
A jövőben várhatóan nagyobb hangsúlyt kapnak a környezetbarát gyártási módszerek, mint például a kevesebb energiát és vizet igénylő folyamatok, a veszélyes oldószerek helyettesítése vízbázisú alternatívákkal, valamint a melléktermékek és hulladékok újrahasznosítása. A „zöld kémia” elveinek alkalmazása segíthet a Litol rubin BK gyártásának fenntarthatóbbá tételében.
Emellett a biológiailag lebomló vagy megújuló forrásokból származó pigmentek kutatása is intenzívebbé válik, bár ezek jelenleg még nem tudják teljes mértékben helyettesíteni a hagyományos szintetikus pigmenteket a teljesítmény és a költséghatékonyság tekintetében. A Litol rubin BK továbbra is kulcsfontosságú lesz, de a gyártóknak alkalmazkodniuk kell a változó környezetvédelmi elvárásokhoz és befektetniük kell a fenntartható fejlesztésekbe.
A Litol rubin BK szerepe a jövőben
A Litol rubin BK valószínűleg továbbra is az egyik legfontosabb vörös pigment marad a piacon, különösen azokon a területeken, ahol a költséghatékonyság és az élénk szín a legfontosabb. A nyomdaiparban, a műanyagiparban és a festékiparban betöltött szerepe stabil marad. Azonban az alkalmazási feltételek és a szabályozások változásával a pigment felhasználása finomodhat, és a gyártóknak folyamatosan alkalmazkodniuk kell.
A digitális nyomtatás térnyerése például új kihívásokat és lehetőségeket teremt a pigmentgyártók számára, mivel a digitális tintákhoz speciális részecskeméret és diszperziós tulajdonságok szükségesek. A Litol rubin BK adaptálása ezekhez az új technológiákhoz biztosíthatja a pigment relevanciáját a jövőben is.
Összefoglalva, a Litol rubin BK egy jól bevált, sokoldalú és gazdaságos pigment, amelynek mélyreható ismerete elengedhetetlen a modern ipari alkalmazásokban. A kémiai szerkezetétől, tulajdonságaitól és felhasználási területeitől kezdve a gyártási és környezetvédelmi szempontokig minden aspektusa hozzájárul ahhoz, hogy ez a rubin vörös árnyalat továbbra is kulcsfontosságú maradjon a színes világunk megteremtésében.
